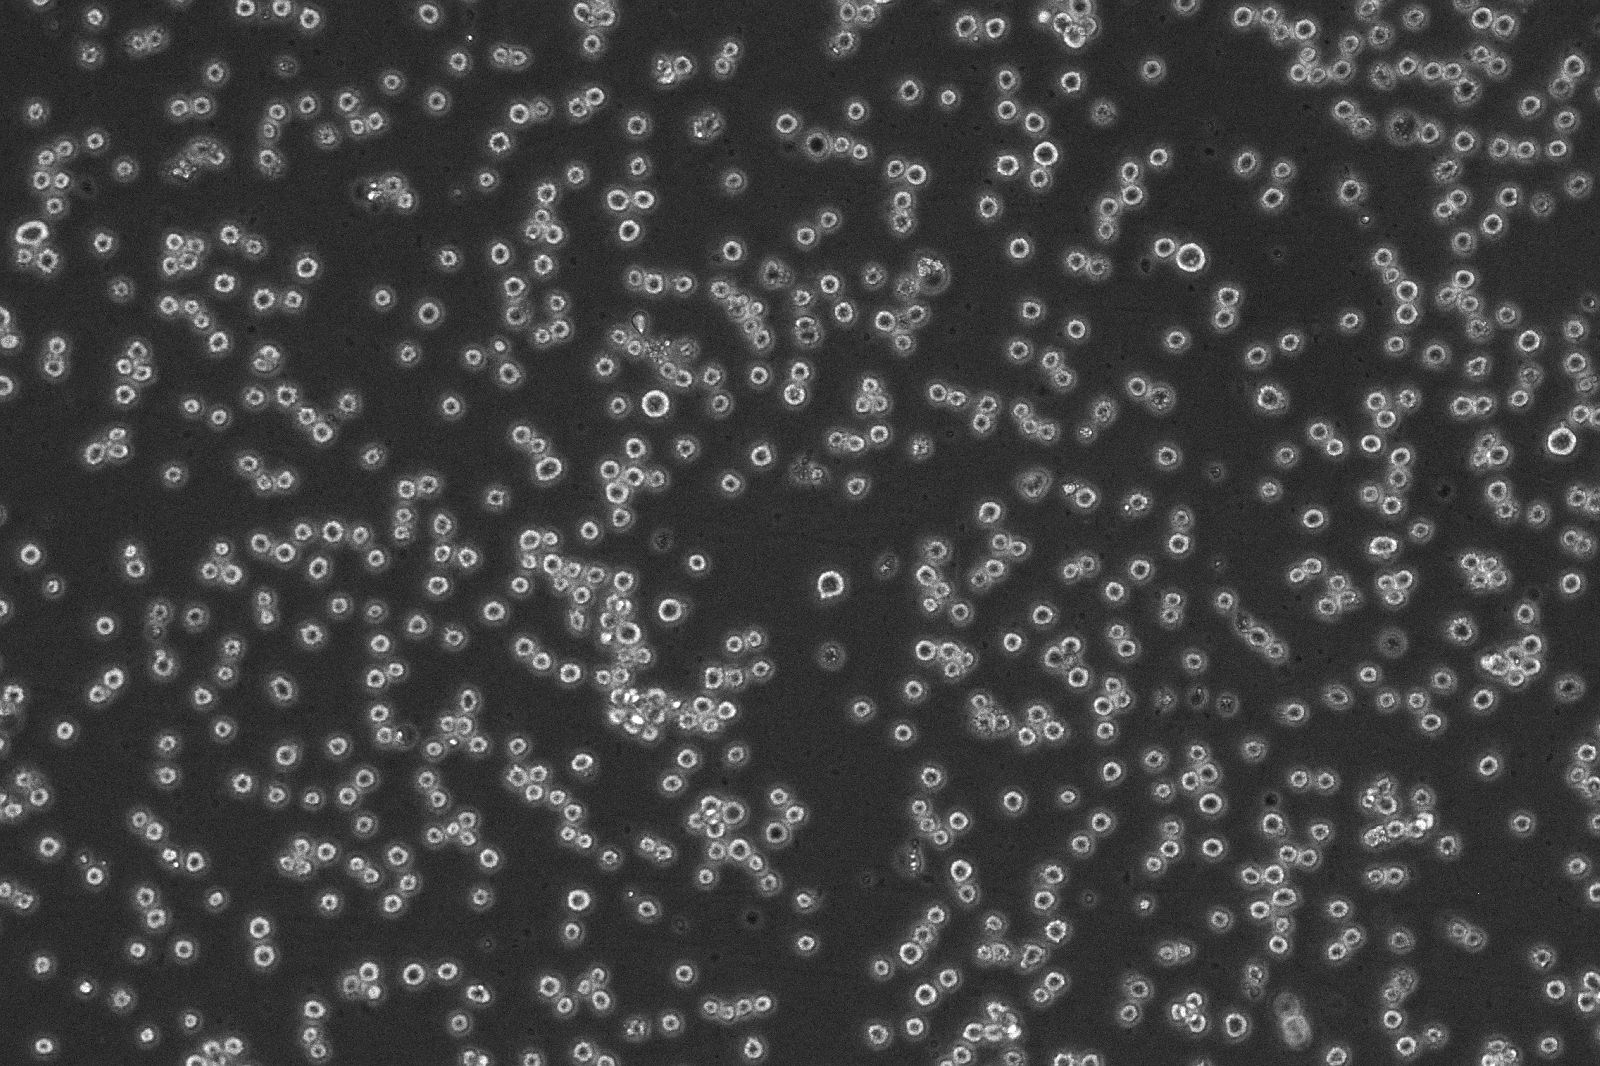
ŷΰHMC-1˷ʴϸ

| | 级别:其它 | | 规格:1×10⁶cells/T25培养瓶 | | 品牌:百欧博伟生物 | |
| | 型号:bio-133200 | | | | | |
微生物菌种查询网是一个专为科研人员进行微生物菌种查询的技术型网站,由包括北京百欧博伟生物技术有限公司在内的多家企事业单位及院所共同打造!网站隶属于北京百欧博伟生物技术有限公司,并由其进行更新维护,会根据资源内容及菌种数量进行不定时更新,旨在将*全面的微生物菌种信息呈现给广大微生物科研技术人员!
从成立之日至今,微生物菌种查询网已收录并更新的国内外菌种资源达12万余株,其中,国内7万余株,国外4万余枚!网站也对细胞资源信息进行了收录,目前达到了国内外细胞资源总量超过1万余枚,基本可以满足大部分科研人员的查询需求!同时我们也罗列了5千余套培养基配方,部分已以文字的形式免费呈现在网站中!而且我们技术人员已经在对常用质粒载体进行设计构建,并且可提供查询的有400余枚!经过工作人员的不懈努力,网站中的资源信息每天都在增加,信息内容每天都在丰富,方便了大批需要进行微生物查询的科研技术人员,满足了众多企事业单位及科研院所的需求!HMC-1人肥大细胞
产品类别:人源细胞系
生长特性:悬浮细胞
培养体系:DMEM+10%FBS
传代方法:
第,一次建议1:2传代
细胞形态:圆形
冻存条件:无血清细胞冻存液
一、细胞培养条件
英文名称Hmc-1中文名称人肥大细胞
生长特性圆形、悬浮冻存条件无血清冻存液
培养体系DMEM+10%FBS
传代方法1:2-1:3,
第,一次建议1:2传代传代情况2~3天换液/传代
备注用无菌离心管收集瓶子培养基,留作过渡培养
二、细胞收到后处理
收到细胞先不开瓶盖,瓶身擦拭酒精后放在培养箱静置若干小时(视细胞密度而定)稳定细胞状态。接着在倒置显微镜下观察细胞生长情况,并对细胞进行不同倍数拍照(建议收细胞时就整体外观拍一张照片,观察培养基的颜色和是否有漏液情况,随后在显微镜下拍下细胞状态,100×,200×各一张),观察记录细胞在运输过程中是否有污染情况。作为我方进行售后的依据。
细胞在培养瓶中培养至良好状态后灌满完全培养液并封好瓶口是细胞运输的*好办法。收到细胞回到自己的实验室后,先打开外包装,用75%酒精喷洒整个瓶消毒后放到超净台内,严格无菌操作,培养箱静置2-4小时。镜下观察:未超过80%汇合度时,可将瓶装的完全培养液收集至离心管中,加入6ml完全培养基,放入37℃、5%CO2孵箱培养;超过80%汇合度时,根据情况传代或者冻存,具体操作见细胞培养步骤。(注意发货的是密封培养瓶的话,放入培养箱培养记得培养瓶盖子拧松)
三、细胞培养步骤
1)复苏细胞:将含有1mL细胞悬液的冻存管在37℃水浴中迅速摇晃解冻,加入5mL培养基混合均匀。在1000RPM条件下离心5分钟,弃去上清液,补加4-6mL完全培养基后吹匀。然后将所有细胞悬液加入培养瓶中培养过夜(或将细胞悬液加入6cm皿中),培养过夜。第二天换液并检查细胞密度。
2)细胞传代:如果细胞密度达80%-90%,即可进行传代培养。
1、对于悬浮细胞,传代可参考以下方法:
方法一:收集细胞,1000RPM条件下离心8-10分钟,弃上清液,补加1-2ml培养液后吹匀,将细胞悬液按1:2到1:5的比例分到新的含8ml培养基的新皿中或瓶中。
方法二:可选择半数换液方式,弃半数培养基后,将剩余细胞悬起,将细胞悬液按1:2到1:3的比例分到新的含8ml培养基新皿中或者瓶中。
PS:若客户收到2ml小管细胞,收到细胞后,用75%酒精喷洒整个管子消毒后放到超净台或安全柜内,严格无菌操作;将小管细胞转移至T25培养瓶或6cm培养皿,加入5ml左右完全培养基混匀,放入培养箱过夜培养后查看细胞密度:若密度未超过80%,换液继续培养,视情况传代或者冻存。若密度超过80%,可直接进行传代(方法同上)。
3)细胞冻存:
1、细胞生长至覆盖培养瓶的80%面积时,弃25cm2培养瓶中的培养液,用PBS清洗细胞一次;
2、添加0.25%胰蛋白酶消化液约1ml至培养瓶中,倒置显微镜下观察,待细胞回缩变圆后加入完全培养液终止消化,轻轻吹打细胞使之脱落,然后将悬液转移至15ml离心管中,1000rpm离心5min;
3、用适量的冻存液重悬细胞,并放置于冻存管中;
4、先将细胞冻存管放置于-20℃1.5h,然后将其移入-80℃。